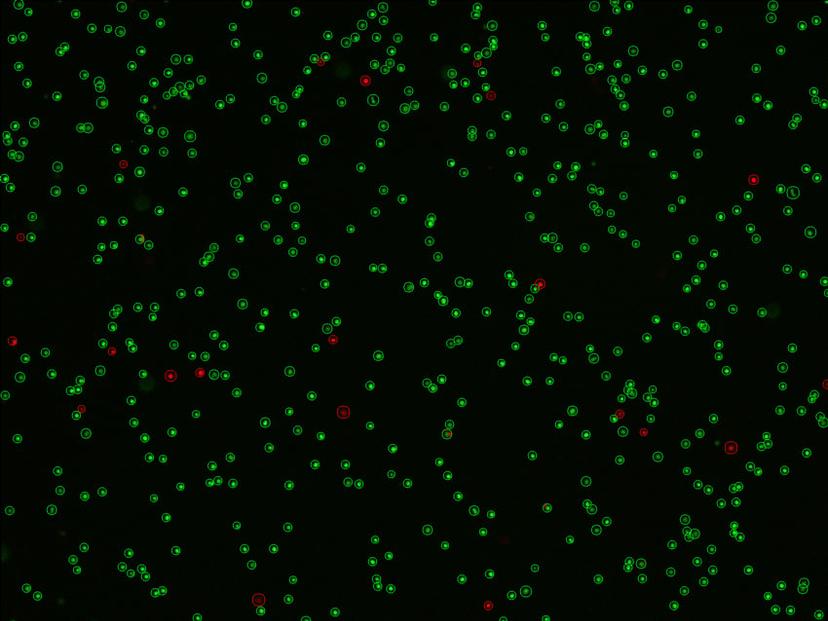
Image of fluorescent green and red cells on a black background

Automated cell counting increases efficiency of neurology research at Yale School of Medicine
Learn how the latest automated cell counting technology is enhancing autoimmune disease research at Yale School of Medicine’s Hafler Lab
11 Jun 2024
Editorial article

Scientists in the Neuroimmunology Lab of Dr. David A. Hafler at Yale School of Medicine are using automated cell counting to increase throughput and enhance cell-based experiments that are providing key insights into the cells responsible for autoimmune neurological diseases.
Neurological diseases affect the central and peripheral nervous systems including the brain, spinal cord, nerves and muscles, resulting in debilitating physical and psychological symptoms. To this day, scientists are still searching for effective treatments for these conditions: stroke, Alzheimer's, Parkinson's, multiple sclerosis (MS), and amyotrophic lateral sclerosis (ALS) are just a few examples of neurological disorders that have no cure. However, advancements in neurological research have significantly expanded our knowledge of the intricate workings of the brain and nervous system, paving the way for the discovery of new treatments.
One laboratory at the forefront of neurology research is the Hafler Lab at Yale School of Medicine, whose trailblazing research is helping improve our understanding of autoimmune neurological diseases. In this article, we speak with Nick Buitrago-Pocasangre, Project Manager at the Hafler Lab, to hear more about his research and the cutting-edge automated cell counting technology that has helped scientists to study important cellular changes associated with neurological disorders.
Improving our understanding of autoimmune diseases
For over 25 years, the Hafler Lab at the Yale School of Medicine has been at the forefront of autoimmune disease research and has provided groundbreaking insights into the immunology and pathogenesis of these conditions. The lab’s current research focuses on characterizing regulatory T cells and their role in autoimmune disease, identifying relevant B cell antigens in MS, investigating TCR signaling cascades, and understanding the role of co-stimulatory molecules in autoimmune disease.
“As Project Manager, my role involves overseeing projects related to basic science research and clinical trial research, with a primary focus on autoimmune diseases like MS, glioblastoma and Parkinson's disease,” Buitrago-Pocasangre explains. “A significant portion of our research revolves around peripheral blood mononuclear cells (PBMCs) which encompass vital immune cells including lymphocytes (T cells, B cells, NK cells) and monocytes. By isolating these cells from patient peripheral blood samples, cerebrospinal fluid (CSF) and brain and skin biopsies, we are able to study the immune system’s involvement in neurological conditions. This helps improve our understanding of neurological diseases and aids in the development of potential new therapeutics.”
Quantify PBMCs with the LUNA-FX7™ automated cell counter
Accurate cell counting of PBMCs is essential for precisely determining cell concentrations, assessing cell viability, informing experimental design, and monitoring changes in immune cell populations associated with neurological disorders. This information provides insights into disease progression and enables scientists to evaluate treatment efficacy. Cell counting is traditionally performed manually, which involves visual inspection of a sample under a microscope and counting cells using a counting chamber or a hemocytometer. However, this method is time-consuming, prone to human error and lacks precision. Recent advancements in technology have introduced automated cell counters that offer higher precision, faster processing times, and the ability to analyze multiple samples simultaneously.
The Hafler Lab use the LUNA-FX7™ Automated Cell Counter by Logos Biosystems for all of its cell counting needs. This instrument offers accuracy, state-of-the-art optics, dual fluorescent and brightfield detection, precise autofocus, and built-in quality control features to ensure reliable monitoring of quality and production, along with the ability to use multiple slide formats including 8-, 3-, 2-, and single chamber slides.
“One project we are currently working on focuses on using frozen PMBCs to study the immune response in individuals with natural COVID infection, which involves running up to 30 samples. Previously, we relied on an automated cell counter which required individual counting of cells, taking significant time and effort. The introduction of the LUNA-FX7™ cell counter has improved the efficiency of our workflow by approximately 10-fold and significantly increased our throughput, as it allows us to run up to eight samples simultaneously,” Buitrago-Pocasangre says.
“My colleagues have also found the cell counter beneficial for their single-cell clone experiments, as they often handle up to 80 samples at a time. The accurate cell counts obtained from the cell counter greatly contribute to the reliability and reproducibility of our experimental results and the efficiency of this piece of equipment is of immense value to us. After exploring other cell counting instruments, it was clear the LUNA-FX7™ was definitely the best on the market.”
Buitrago-Pocasangre shares that he is also impressed by the flexibility the LUNA-FX7™ automated cell counter provides in terms of cell viability staining options, as it offers both acridine orange/propidium iodide (AO/PI), which is a more advanced and accurate technology, and Trypan blue, which may be preferred by users with prior experience using this traditional staining method. He explains that the LUNA-FX7™ also provides convenient data management, allowing for easy transfer of all collected data via the internet instead of having to manually record data. This saves time and improves efficiency, especially when dealing with large batch files, and reduces the risk of human error. And, because the LUNA-FX7™ has ample storage capacity all data can be stored for up to a year.
Buitrago-Pocasangre is also appreciative of the support he has received from Logos Biosystems, he adds, “the quality of customer service from Logos Biosystems played a significant role in my decision to choose the LUNA-FX7™ machine. As someone responsible for managing the lab and handling purchasing, I understand the importance of not only the price point but also the ability to communicate effectively with a representative. The customer service I experienced during the buying process was outstanding. The representative was highly responsive, engaging in effective back-and-forth communication, and demonstrated a genuine effort to ensure my satisfaction with the purchase.”
The future of neurology research
As neurology research continues to advance, Buitrago-Pocasangre says he is starting to observe a trend where different neurological disorders, despite their distinct manifestations, are showing potential similarities in terms of their underlying phenotypes. He says, “this intriguing development is unfolding in real-time within our lab. As a young scientist, I have long pondered the possibility that autoimmune diseases might share fundamental characteristics. The research in our lab reinforces this idea and it is conceivable that in the coming months or years, we will witness the publication of papers highlighting the discovery of shared aspects among these seemingly dissimilar diseases.”
This growing understanding of commonalities in phenotypes holds immense promise for the future of neurology research. Uncovering these shared patterns enables scientists to gain deeper insights into the underlying mechanisms of neurological disorders, which could potentially lead to the development of innovative treatments that target these common pathways, even in diseases that present themselves differently.

